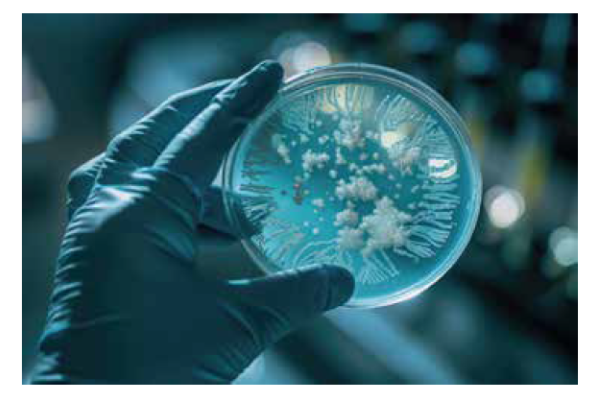

Legionellose é o termo usado para infecções causas pela bactéria Legionellapneumophila e outras bactérias da família Legionellacea
Legionellose é o termo usado para infecções causas pela bactéria Legionellapneumophila e outras bactérias da família Legionellacea
A doença dos Legionários é uma pneumonia que afeta principalmente a todos aqueles que são suscetíveis devido à idade, doenças, imunossupressão, tabagismo, dentre outros, e pode ser fatal. Legionella também pode causar outras sérias enfermidades, como a Febre Pontiac, que afetam as pessoas. Os sintomas iniciais incluem febre alta, calafrios, dor de cabeça e dores musculares. Os pacientes podem desenvolver uma tosse seca com dificuldades de respiração. Um terço dos pacientes contaminados ainda apresenta um quadro de vômito e diarreia e a metade apresenta confusão mental e até delírios. O risco aumenta para a população masculina, fumante, acima dos 40 anos. Os principais fatores de crescimento da bactéria são a temperatura, entre 20°C e 45°C, a presença de nutrientes e água estagnada. O índice de letalidade da doença em sua forma mais grave gira em torno de 12%, podendo chegar a 20% entre a população suscetível.
No Brasil existe pouca ou nenhuma informação sobre a incidência da doença. Entre 1990 e 1993, a unidade de nefrologia do Hospital das Clínicas de São Paulo teve vários casos comprovados de Legionellose, inclusive com óbitos, mas é um dos raros casos documentado existente no país. O CDC (Center for Disease Control and Prevention) estima que entre 10.000 e 20.000 casos de Doença dos Legionários ocorram a cada ano nos Estados Unidos. Desses, só 1.500 a 1.800 são notificados às autoridades sanitárias. Na Inglaterra, 150 a 200 casos são notificados anualmente, mas a estimativa é que na realidade o número de casos gire em torno de 1.100 por ano. Desde 1990 foram descritos 54 surtos de Legionellose na Espanha, afetando um total de 805 pessoas. Na França, o Hospital Georges Pompidou foi temporariamente interditado em julho de 2001 até conseguir manter sob controle os casos de Legionellose, 6 deles fatais.
A infecção é atribuída a inalação da Legionella em pequenas gotículas de água, que são pequenas o suficiente (<5µm) para penetrar profundamente no pulmão.
As torres de resfriamento são os primeiros locais de suspeita, devido a sua tendência a emitir vapores, mas a bactéria se desenvolve em muitos outros tipos de sistemas, inclusive os sistemas de distribuição de água potável e de água de processo.
A estratégia a ser usada contra a disseminação da bactéria é a minimização dos riscos provocados pela Legionella. Como resultado de nossa experiência, desenvolvemos um plano de gerenciamento de risco e um processo para avaliar e minimizar os riscos relativos à saúde. Nosso programa divide-se em três etapas principais:
Análise de Risco: Levantamento em campo das instalações, dos fatores operacionais, dos fatores de risco de proliferação e disseminação da bactéria, e da população suscetível de risco. A extensiva documentação gerada cobre os riscos gerais da unidade, mas também de cada sistema individual, apresentando recomendações e planos de ação que permitem o desenvolvimento de um plano de gerenciamento do risco;
Implementação das recomendações fornecidas na Análise de Risco;
Monitoramento e controle: para assegurar a eficácia das recomendações e ações que tenham sido implantadas para minimizar os riscos relativos à Legionella. É parte de uma estratégia contínua de gerenciamento de risco, que permite que se concentre em suas principais competências.
Legislação
A análise de risco de legionellose na Inglaterra é exigida pela Saúde e Segurança no Trabalho criado em 1974 e o Controle de Substâncias Perigosas para Regulamentação da Saúde de 1994.No Brasil não existe legislação que exija a análise de risco.De acordo com a legislação inglesa a análise de risco deve conter:
– Identificar fontes de risco,
– Preparar um plano para prevenção ou monitoramento de risco,
– Implementar e gerenciar prevenções,
– Manter arquivos de prevenções implementadas,
– Apontar a pessoa responsável pelo gerenciamento do programa.
A metodologia e apresentação detalhada da análise de risco ficam, entretanto, a critério do inspetorde risco.
Análise de Risco (Risk Assessment)
Ferramenta destinada a realizar um levantamento preciso e uma revisão regular dos sistemas de água e documentar as mudanças à medida que elas ocorrem, com enfoque no risco relativo de transmissão da bactéria Legionella. Essa avaliação foi desenvolvida de acordo com práticas e orientações correntes para o controle da Legionella, emitidas pela OccupationalSafety and Health Administration (OSHA), pelos Centers for DiseaseControl and Prevention (CDC), pelo Cooling Tower Institute (CTI), pela American Society ofHeating, Refrigeration and Air ConditioningEngineers (ASHRAE) e pela Health and Safety Commission (HSC) no Reino Unido (País em que vigora uma legislação específica para o controle da Legionella).
Análises realizadas, para cada sistema na planta, durante o levantamento
– Análise microbiológica para contagem total de bactérias durante o levantamento;
– Análise microbiológica para pesquisa de Legionella (quantitativa e qualitativa), durante o levantamento;
– Procedimento ISO 11731:1998. WaterQualityDetection and Enumeration For Legionella. International Standard. (Metodologia padrão dentro do programa de laboratórios credenciados pelo UKAS).
Monitoramento
– Visitas trimestrais para inspeção das instalações, verificação das condições do tratamento do sistema implementado;
– Análise microbiológica trimestral para contagem total de bactérias;
– Análise microbiológica trimestral para pesquisa de Legionella (quantitativa e qualitativa), trimestral;
– Procedimento ISO 11731:1998. WaterQualityDetection and Enumeration For Legionella. International Standard. (Metodologia padrão dentro do programa de laboratórios credenciados pelo UKAS).
Controle (Log Book): implantação do livro de registro de todas as atividades de monitoramento realizadas durante o ano, por site.
O DNTA Abrava possui profissionais capacitados para identificar o grau de risco e proporcionar as melhores soluções para minimizá-los.
Sérgio Belleza é químico industrial e diretor técnico-comercial da Bellacqua Soluções Ambientais







